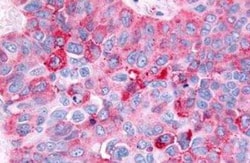
Histamine H4R Antibody - BSA Free, Novus Biologicals 0.05 mL, Unconjugated:Antibodies,

missing translation for 'onlineSavingsMsg'
Learn More
Learn More
Histamine H4R Antibody - BSA Free, Novus Biologicals™
Rabbit Polyclonal Antibody
Brand: Novus Biologicals NLS3775
462.40 EUR valid until 2025-12-16
BEST PRICE on Promo! Use promo code "24090" to get your promotional price.
This item is not returnable.
View return policy
Description
Histamine H4R Polyclonal antibody specifically detects Histamine H4R in Human, Monkey samples. It is validated for Immunohistochemistry, Immunocytochemistry/ Immunofluorescence, Immunohistochemistry (Paraffin)
Specifications
| Histamine H4R | |
| Polyclonal | |
| Unconjugated | |
| PBS | |
| AXOR35H4, GPCR105MGC133027, G-protein coupled receptor 105, GPRv53histamine H4 receptor, H4Rpfi-013, HH4RBG26, histamine receptor H4, Pfi-013, SP9144 | |
| Synthetic 18 amino acid peptide from 1st cytoplasmic domain of human Histamine H4R. | |
| 0.05 mL | |
| GPCR, Immunology, Innate Immunity | |
| 59340 | |
| Keep as concentrated solution. Aliquot and store at -20°C or below. Avoid multiple freeze/thaw cycles. | |
| IgG |
| Immunohistochemistry, Immunofluorescence, Immunohistochemistry (Paraffin) | |
| 1.0 mg/mL | |
| Immunohistochemistry, Immunocytochemistry/ Immunofluorescence, Immunohistochemistry-Paraffin 20 μg/mL | |
| Q9H3N8 | |
| Rabbit | |
| Immunogen affinity purified | |
| RUO | |
| Primary | |
| Human, Monkey | |
| Purified |
Product Content Correction
Your input is important to us. Please complete this form to provide feedback related to the content on this product.
Product Title
Spot an opportunity for improvement?Share a Content Correction